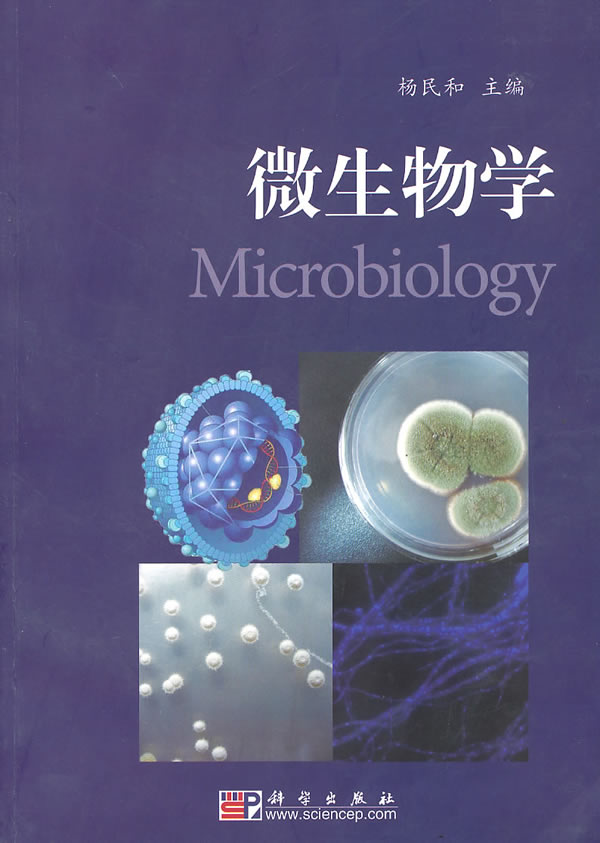
微生物学

微生物学

微生物学
图片尺寸1913x1080
微生物学
图片尺寸356x500
微生物学(第2版)
图片尺寸600x796
《微生物学(第8版)》
图片尺寸1646x2281
再也不用担心考试挂了微生物学名词解释
图片尺寸1080x1440
微生物学
图片尺寸800x1118
微生物学,插画
图片尺寸1023x804
正版现货 微生物学9787030280572
图片尺寸1000x1000
微生物学
图片尺寸600x851
微生物学
图片尺寸600x843
微生物学,插画
图片尺寸1024x836
天地图书专营店:现货包邮 微生物学教程 第4版 第四版 周德庆 十二五
图片尺寸430x430
微生物学(第2版)/普通高等教育"十一五"国家级规划教材
图片尺寸960x1165
微生物学杂志
图片尺寸826x1077
科学家微生物学实验室测试
图片尺寸1280x683
微生物学a
图片尺寸510x288
微生物学教学课件:第一章 原核微生物的形态,构造和功能_第5页
图片尺寸1500x1125
微生物学,插画
图片尺寸1023x804细胞微生物细菌生物学图片
图片尺寸650x613
微生物学_微生物学图片
图片尺寸600x450